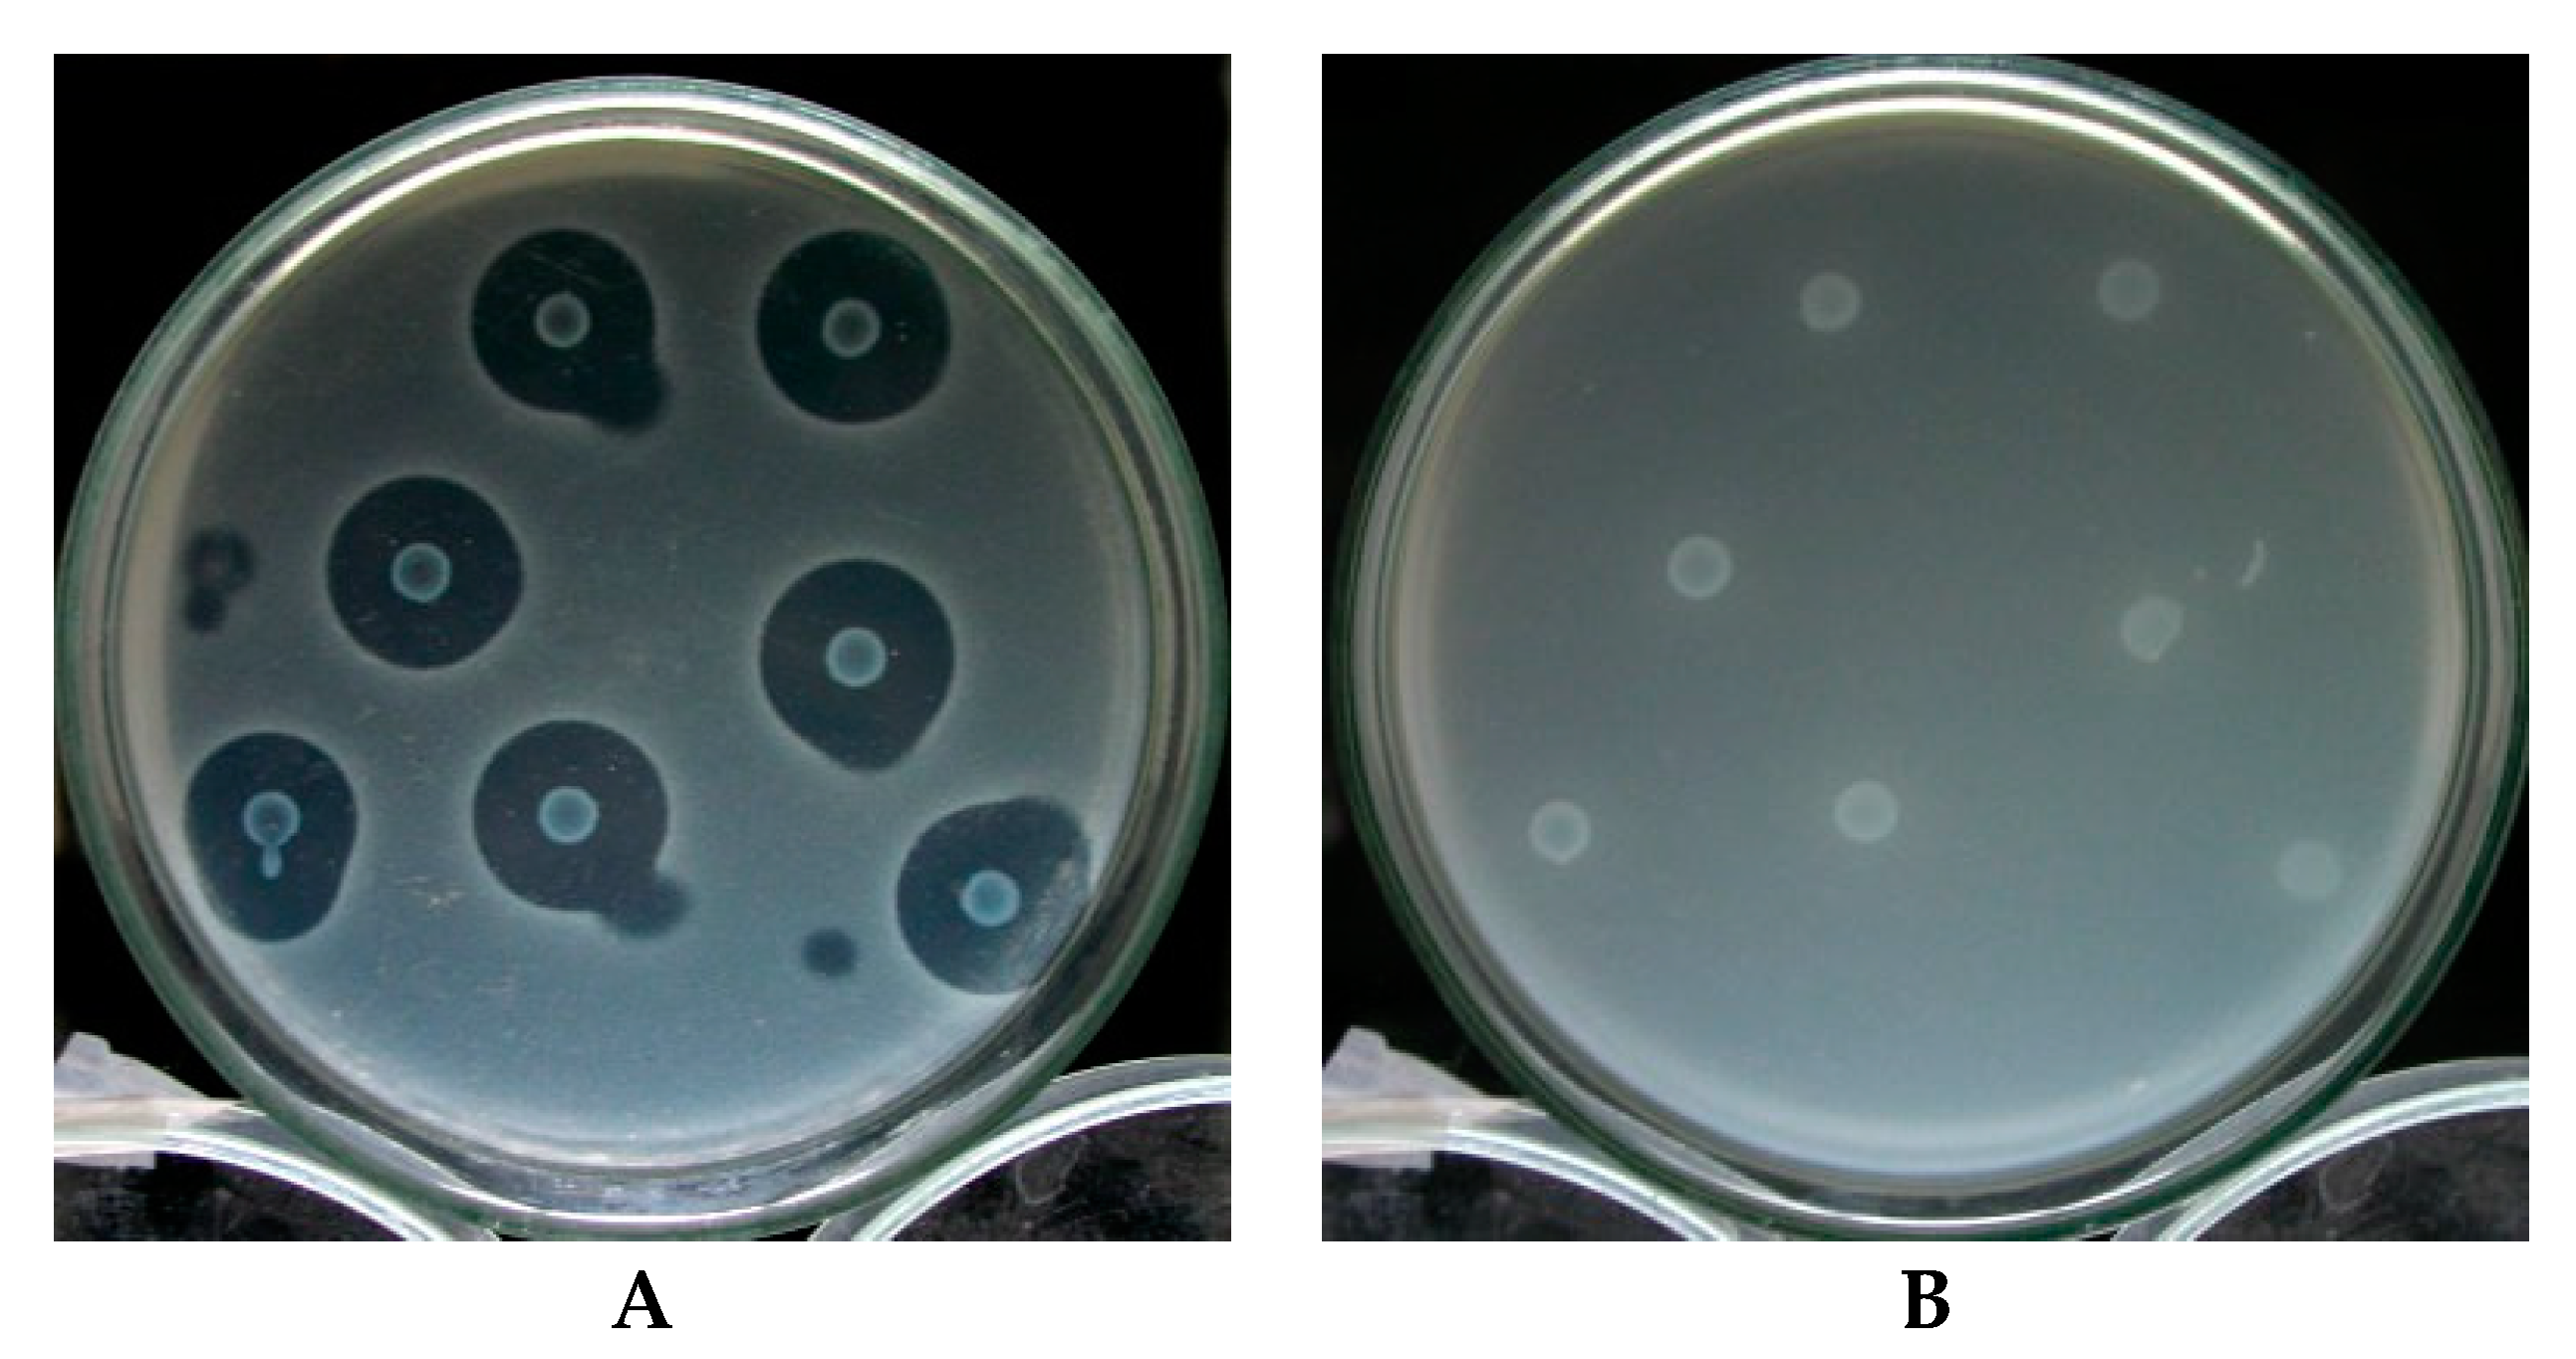
Microorganisms 11 01854 g011 Microorganisms 11 01854 g011

A Novel Deoxyribonuclease Low-Molecular-Weight Bacteriocin, Carocin S4, from Pectobacterium carotovorum subsp. carotovorum
Abstract
1. Introduction
2. Materials and Methods
3. Results
3.1. Selection of Bacteriocin-Producing Strains
3.2. Isolation and Detection of Transposon Tn5 Mutants
3.3. Amplification of the Gene Blocked by Transposon Tn5 Using the TAIL-PCR Method
3.4. Bacterial Gene Selection and Bacteriocin Activity Test
3.5. Transcriptional Analysis and In Vivo Expression of the Carocin S4 Gene
3.6. Purification and Characterization of the Carocin S4 Gene
3.7. DNase Activity of CaroS4K with Varying Times and Temperatures
3.8. The Activity Relationship between the Divalent Metal Ions Ca2+, Mg2+, Cu2+, and Zn2+ and CaroS4K
4. Discussion
5. Conclusions
Supplementary Materials
Author Contributions
Funding
Institutional Review Board Statement
Informed Consent Statement
Data Availability Statement
Conflicts of Interest
References
- Wang, J.W.; Derilo, R.C.; Lagitnay, R.S.; Wu, H.P.; Chen, K.I.; Chuang, D.Y. Identification and characterization of the bacteriocin Carocin S3 from the multiple bacteriocin producing strain of Pectobacterium carotovorum subsp. carotovorum. BMC Microbiol. 2020, 20, 273. [Google Scholar] [CrossRef] [PubMed]
- Lund, B.M. Formation of reducing sugars from sucrose by Erwinia species. J. Gen. Microbiol. 1975, 88, 367–371. [Google Scholar] [CrossRef] [PubMed]
- Lund, B.M.; Wyatt, G.M. The nature of reducing compounds formed from sucrose by Erwinia carotovora var. atroseptica. J. Gen. Microbiol. 1973, 78, 331–336. [Google Scholar] [CrossRef]
- Malcolmson, J.F. A study of Erwinia isolates obtained from soft rots and blackleg of potatoes. Trans. Brit. Mycol. Soc. 1959, 42, 261–269. [Google Scholar] [CrossRef]
- Phillips, J.A.; Kelman, A. Direct fluorescent antibody stain procedure applied to insect transmission of Erwinia carotovora. Phytopathology 1982, 72, 898–901. [Google Scholar] [CrossRef]
- Kloepper, J.W.; Harrison, M.D.; Brewer, J.W. The association of Erwinia carotovora var. atroseptica and Erwinia carotovora var. carotovora with insects in Colorado. Am. Potato J. 1979, 56, 351–361. [Google Scholar] [CrossRef]
- Campos, E.; Maher, E.A.; Kelman, A. Relationship of Pectolytic clostridia and Erwinia carotovora strains to decay of potato tubers in storage. Plant Dis. 1982, 6, 543–546. [Google Scholar] [CrossRef]
- Jones, R.D.; Dowson, W.J. On the bacteria responsible for soft-rot in stored potatoes and the relation of the tuber to invasion by Bacterium carotovorum (Jones) Lehmann and Neumann. Ann. Appl. Biol. 1950, 37, 563–569. [Google Scholar] [CrossRef]
- Itoh, Y.; Izaki, K.; Takahashi, H. Purification and characterization of a bacteriocin from Erwinia carotovora. J. Gen. Appl. Microbiol. 1978, 24, 27–39. [Google Scholar] [CrossRef]
- Jabeen, N.; Rasool, S.A.; Ahmad, S.; Ajaz, M.; Saeed, S. Isolation, identification and bacteriocins production by indigenous diseased plant and soil-associated bacteria. P. J. Biol. Sci. 2004, 7, 1893–1897. [Google Scholar] [CrossRef]
- Jack, R.W.; Tagg, J.R.; Ray, B. Bacteriocins of gram-positive bacteria. Microbiol. Rev. 1995, 59, 171–200. [Google Scholar] [CrossRef]
- Cascales, E.; Buchanan, S.K.; Duché, D.; Kleanthous, C.; Lloubes, R.; Postle, K.; Riley, M.; Slatin, S.; Cavard, D. Colicin biology. Microbiol. Mol. Biol. Rev. 2007, 71, 158–229. [Google Scholar] [CrossRef]
- Sørensen, K.I.; Larsen, R.; Kibenich, A.; Junge, M.P.; Johansen, E. A food-grade cloning system for industrial strains of Lactococcus lactis. Appl. Environ. Microbiol. 2000, 66, 1253–1258. [Google Scholar] [CrossRef] [PubMed]
- Strauch, E.; Kaspar, H.; Schaudinn, C.; Dersch, P.; Madela, K.; Gewinner, C.; Hertwig, S.; Wecke, J.; Apple, B. Characterization of enterocoliticin, a phage tail-like bacteriocin, and its effect on pathogenic Yersinia enterocolitica strains. Appl. Environ. Microbiol. 2001, 67, 5634–5642. [Google Scholar] [CrossRef] [PubMed]
- Hurst, A. Nisin. Advances Appl. Microbiol. 1981, 27, 85–123. [Google Scholar]
- Bennik, M.H.; Verheul, A.; Abee, T.; Naaktgeboren-Stoffels, G.; Gorris, L.G.; Smid, E.J. Interactions of nisin and pediocin PA-1 with closely related lactic acid bacteria that manifest over 100-fold differences in bacteriocin sensitivity. Appl. Environ. Microbiol. 1997, 63, 3628–3636. [Google Scholar] [CrossRef] [PubMed]
- Chuang, D.Y.; Chien, Y.C.; Wu, H.P. Cloning and expression of the Erwinia carotovora subsp. carotovora gene encoding the low-molecular-weight bacteriocin carocin S1. J. Bacteriol. 2007, 189, 620–626. [Google Scholar] [CrossRef] [PubMed]
- Chan, Y.C.; Wu, J.L.; Wu, H.P.; Tzeng, K.C.; Chuang, D.Y. Cloning, purification, and functional characterization of Carocin S2, a ribonuclease bacteriocin produced by Pectobacterium carotovorum. BMC Microbiol. 2011, 11, 99. [Google Scholar] [CrossRef]
- Gantotti, B.V.; Kindle, K.L.; Beer, S.V. Transfer of the drug-resistance transposon Tn5 to Erwinia herbicola and the induction of insertion mutations. Curr. Microbiol. 1981, 6, 377–381. [Google Scholar] [CrossRef]
- Fredericq, P. Colicins. Annu. Rev. Microbiol. 1957, 11, 7–22. [Google Scholar] [CrossRef]
- Kado, C.I.; Liu, S. Rapid procedure for detection and isolation of large and small plasmids. J. Bacteriol. 1981, 145, 1365–1373. [Google Scholar] [CrossRef]
- Miyashita, K. DNA Probes: Experimental Methods in Soil Microbiology; Soil Microbiological Society of Japan; Youkendou Publishing Co.: Tokyo, Japan, 1992; pp. 163–172. (In Japanese) [Google Scholar]
- Shi, W.; Zhou, Y.; Wild, J.; Adler, J.; Gross, C.A. DnaK, DnaJ, and GrpE are required for flagellum synthesis in Escherichia coli. J. Bacteriol. 1992, 174, 6256–6263. [Google Scholar] [CrossRef] [PubMed]
- Sambrook, J.; Fritsch, E.F.; Maniatis, T. Molecular Cloning: A Laboratory Manual, 2nd ed.; Cold Spring Harbor Laboratory Press: New York, NY, USA, 1989. [Google Scholar]
- Liu, Y.G.; Whittier, R.F. Thermal asymmetric interlaced PCR: Automatable amplification and sequencing of insert end fragments from P1 and YAC clones for chromosome walking. Genomics 1995, 25, 674–681. [Google Scholar] [CrossRef] [PubMed]
- Hanahan, D. Studies on transformation of Escherichia coli with plasmids. J. Mol. Biol. 1983, 166, 557–580. [Google Scholar] [CrossRef] [PubMed]
- Wood, W.B. Host specificity of DNA produced by Escherichia coli: Bacterial mutations affecting the restriction and modification of DNA. J. Mol. Biol. 1966, 16, 118–133. [Google Scholar] [CrossRef]
- Nakano, Y.; Yoshida, Y.; Yamashita, Y.; Koga, T. Construction of a series of pACYC-derived plasmid vectors. Gene 1995, 162, 157–158. [Google Scholar] [CrossRef]
- Bolivar, F.; Rodriguez, R.L.; Greene, P.J.; Betlach, M.C.; Heynker, H.L.; Boyer, H.W.; Crosa, J.H.; Falkow, S. Construction and characterization of new cloning vehicles II: A multipurpose cloning system. Biotechnol. (Read. Mass.) 1997, 24, 153–171. [Google Scholar] [CrossRef]
- Hockett, K.L.; Baltrus, D.A. Use of the soft-agar overlay technique to screen for bacterially produced inhibitory compounds. J. Vis. Exp. 2017, 119, 55064. [Google Scholar] [CrossRef]
- Yao, G.; Fang, X.; Yokota, H.; Yanagida, T.; Tan, W. Monitoring molecular beacon DNA probe hybridization at the single-molecule level. Chem. Eur. J. 2003, 9, 686–692. [Google Scholar] [CrossRef]
- Tagg, J.R.; Dajani, A.S.; Wannamaker, L.W. Bacteriocins of gram-positive bacteria. Bacteriol. Rev. 1976, 40, 722–756. [Google Scholar] [CrossRef]
- Lazdunski, C.J.; Bouveret, E.; Rigal, A.; Journet, L.; Lloubès, R.; Bénédetti, H. Colicin import into Escherichia coli cells. J. Bacteriol. 1998, 180, 4993–5002. [Google Scholar] [CrossRef] [PubMed]
- Chuang, D.Y.; Kyeremeh, A.G.; Gunji, Y.; Takahara, Y.; Ehara, Y.; Kikumoto, T. Identification and cloning of an Erwinia carotovora subsp. carotovora bacteriocin regulator gene by insertional mutagenesis. J. Bacteriol. 1999, 181, 1953–1957. [Google Scholar] [CrossRef] [PubMed]
- James, R.; Kleanthous, C.; Moore, G.R. The biology of E colicins: Paradigms and paradoxes. Microbiology 1996, 142, 1569–1580. [Google Scholar] [CrossRef]
- Graille, M.; Mora, L.; Buckingham, R.H.; van Tilbeurgh, H.; de Zamaroczy, M. Structural inhibition of the colicin D tRNase by the tRNA-mimicking immunity protein. EMBO J. 2004, 23, 1474–1482. [Google Scholar] [CrossRef]
- Ogawa, T.; Tomita, K.; Ueda, T.; Watanabe, K.; Uozumi, T.; Masaki, H. A cytotoxic ribonuclease targeting specific transfer RNA anticodons. Science 1999, 283, 2097–2100. [Google Scholar] [CrossRef] [PubMed]

| Element | Mass | Measured Value of Blank (ppb) | Measured Value of CaroS4K (ppb) | CaroS4K: Metal |
|---|---|---|---|---|
| Mg | 24.31 | 2.061 | 88.03 | 1: 0.7073 |
| Ca | 40.08 | 46.54 | 870.2 | 1: 4.110 |
| Cr | 52.00 | <0.013 | 0.815 | 1: 3.135 × 10−3 |
| Mn | 54.94 | <0.003 | 5.543 | 1: 0.02018 |
| Fe | 55.85 | <0.094 | 11.08 | 1: 0.03968 |
| Ni | 58.69 | <0.009 | 8.482 | 1: 0.03013 |
| Cu | 63.55 | 4.457 | 69.90 | 1: 0.2060 |
| Zn | 65.38 | 2.292 | 52.96 | 1: 0.1550 |
| Cs | 132.9 | <0.001 | 0.035 | 1: 5.3 × 10−5 |
| Ba | 137.3 | 0.054 | 0.658 | 1: 8.80 × 10−4 |
| Pb | 207.2 | 0.067 | 1.464 | 1: 1.34 × 10−3 |
Disclaimer/Publisher’s Note: The statements, opinions and data contained in all publications are solely those of the individual author(s) and contributor(s) and not of MDPI and/or the editor(s). MDPI and/or the editor(s) disclaim responsibility for any injury to people or property resulting from any ideas, methods, instructions or products referred to in the content. |
© 2023 by the authors. Licensee MDPI, Basel, Switzerland. This article is an open access article distributed under the terms and conditions of the Creative Commons Attribution (CC BY) license (https://creativecommons.org/licenses/by/4.0/).
Share and Cite
Wu, H.-P.; Derilo, R.C.; Hsu, S.-H.; Hu, J.-M.; Chuang, D.-Y. A Novel Deoxyribonuclease Low-Molecular-Weight Bacteriocin, Carocin S4, from Pectobacterium carotovorum subsp. carotovorum. Microorganisms 2023, 11, 1854. https://doi.org/10.3390/microorganisms11071854
Wu H-P, Derilo RC, Hsu S-H, Hu J-M, Chuang D-Y. A Novel Deoxyribonuclease Low-Molecular-Weight Bacteriocin, Carocin S4, from Pectobacterium carotovorum subsp. carotovorum. Microorganisms. 2023; 11(7):1854. https://doi.org/10.3390/microorganisms11071854
Chicago/Turabian StyleWu, Huang-Pin, Reymund C. Derilo, Shih-Hao Hsu, Jia-Ming Hu, and Duen-Yau Chuang. 2023. "A Novel Deoxyribonuclease Low-Molecular-Weight Bacteriocin, Carocin S4, from Pectobacterium carotovorum subsp. carotovorum" Microorganisms 11, no. 7: 1854. https://doi.org/10.3390/microorganisms11071854
APA StyleWu, H.-P., Derilo, R. C., Hsu, S.-H., Hu, J.-M., & Chuang, D.-Y. (2023). A Novel Deoxyribonuclease Low-Molecular-Weight Bacteriocin, Carocin S4, from Pectobacterium carotovorum subsp. carotovorum. Microorganisms, 11(7), 1854. https://doi.org/10.3390/microorganisms11071854

